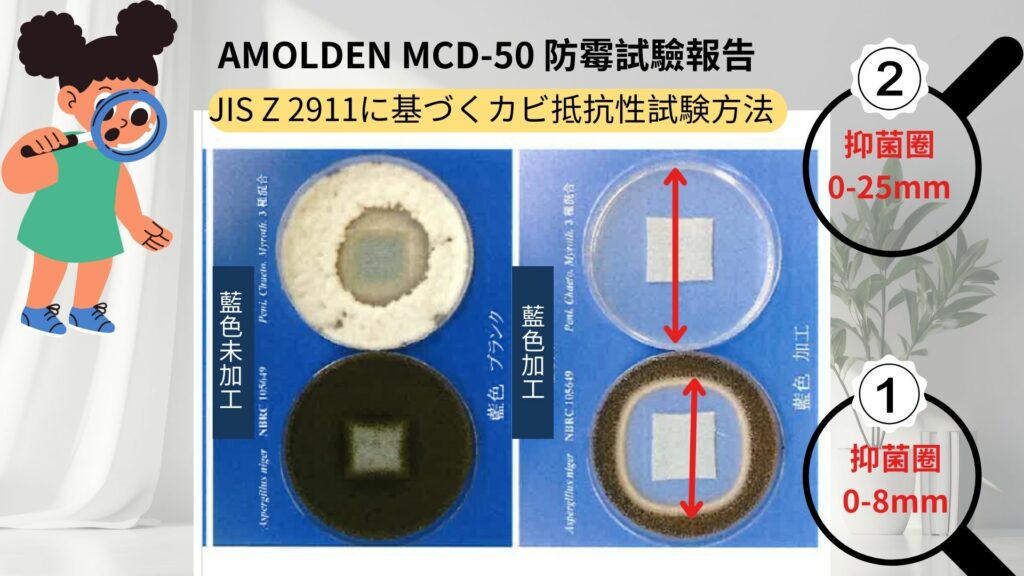

悶熱潮濕的夏天,霉味也悄悄入侵…
近日南台灣多出現颱風暴雨,濕氣重、衣物不易乾,不僅讓人感到黏膩,更讓黴菌有機可乘,在衣物、織品中悄悄滋長。一打開衣櫃,那股難以忽視的霉味,正是黴菌活躍的警訊。
您的客戶正在對「霉味」皺眉頭
在潮濕的氣候中,尤其是颱風暴雨過後,空氣中的濕氣大幅增加,為黴菌提供了理想的生長環境。這些微小的生物會迅速繁殖,並在衣物、傢飾布、鞋材和紙品等材料上形成斑點和異味,嚴重影響產品的品質和使用體驗。
黴菌不僅會讓產品出現難聞的霉味,還會導致材料變質、褪色和破損,降低產品的使用壽命。更重要的是,這些問題會直接影響消費者的購買意願,對品牌形象造成不可挽回的傷害。
這種因潮濕導致的黴菌問題在各行各業都普遍存在,從紡織品到家居用品,從紙張到塗料,幾乎沒有哪個領域能夠倖免。因此,找到一種有效的解決方案已經成為市場的迫切需求。


產品核心優勢
與傳統芳香劑相比,由日本大和化學工業研發的高效防黴劑【AMOLDEN MCD-50】不僅能從源頭抑制黴菌生長,真正解決問題,而不是僅僅掩蓋氣味,還具備出色的耐久性,能夠耐受高達 150°C 的加工溫度,即使經過多次水洗,其防黴效果依然穩定,為產品提供長期的保護。
此外,它適用於纖維、無紡布、紙類、樹脂、塗料等多種材料,應用範圍極其廣泛,能夠滿足不同行業的需求。
AMOLDEN MCD-50 具有低毒性,安全性高,並且有豐富的技術報告和數據支持,可以幫助產品通過相關認證,為您的產品提供強有力的技術保障。

👉想讓衣物與居家環境重現清新?從選對防黴劑開始!我們提供客製化服務與技術報告支援,歡迎聯繫我們獲取專業解決方案。